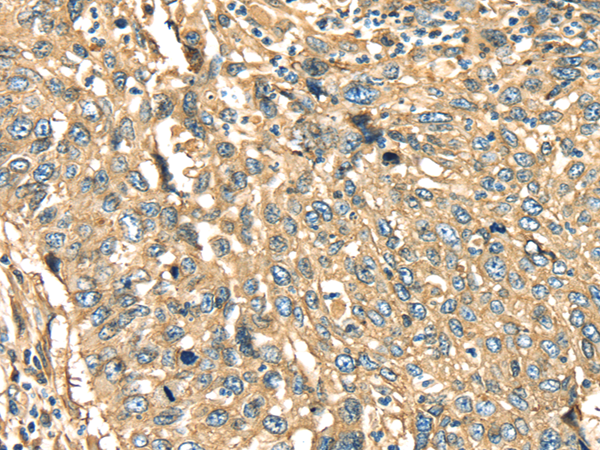

-
分类: 科研抗体货号: P06980别名: ATR; TEM8应用: WB,IHC反应种属: Human, Mouse, Rat
-
分类: 科研抗体货号: P06981别名: P36; ANX2; LIP2; LPC2; CAL1H; LPC2D; ANX2L4; PAP-IV; HEL-S-270应用: WB,IHC反应种属: Human, Mouse, Rat
-
分类: 科研抗体货号: P07002别名: STAT5应用: WB,IHC反应种属: Human, Mouse, Rat
-
分类: 科研抗体货号: P06979别名: ALS9; HEL168; RNASE4; RNASE5应用: WB反应种属: Human
-
分类: 科研抗体货号: P07001别名: SLEB11应用: WB,IHC反应种属: Human, Mouse
-
分类: 科研抗体货号: P07017别名:应用: IHC反应种属: Human
-
分类: 科研抗体货号: P07000别名: MGF, STAT5应用: WB,IHC反应种属: Human, Mouse, Rat
-
分类: 科研抗体货号: P07015别名: CD288应用: IHC反应种属: Human, Mouse
-
分类: 科研抗体货号: P06999别名: ISGF-3, STAT91应用: IHC反应种属: Human, Mouse
-
分类: 科研抗体货号: P07014别名: TLR7-like应用: IHC反应种属: Human, Mouse

鄂公网安备42018502007531号
鄂公网安备42018502007531号

